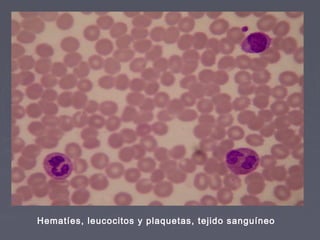
Hematíes, leucocitos y plaquetas, tejido sanguíneo

Los tejidos animales están formados por células especializadas unidas entre sí o inmersas en una sustancia intercelular. Existen cuatro tipos principales de tejidos: epitelial, conectivo, muscular y nervioso. Cada tejido cumple funciones diferentes como la protección, soporte, secreción o transmisión de impulsos nerviosos.